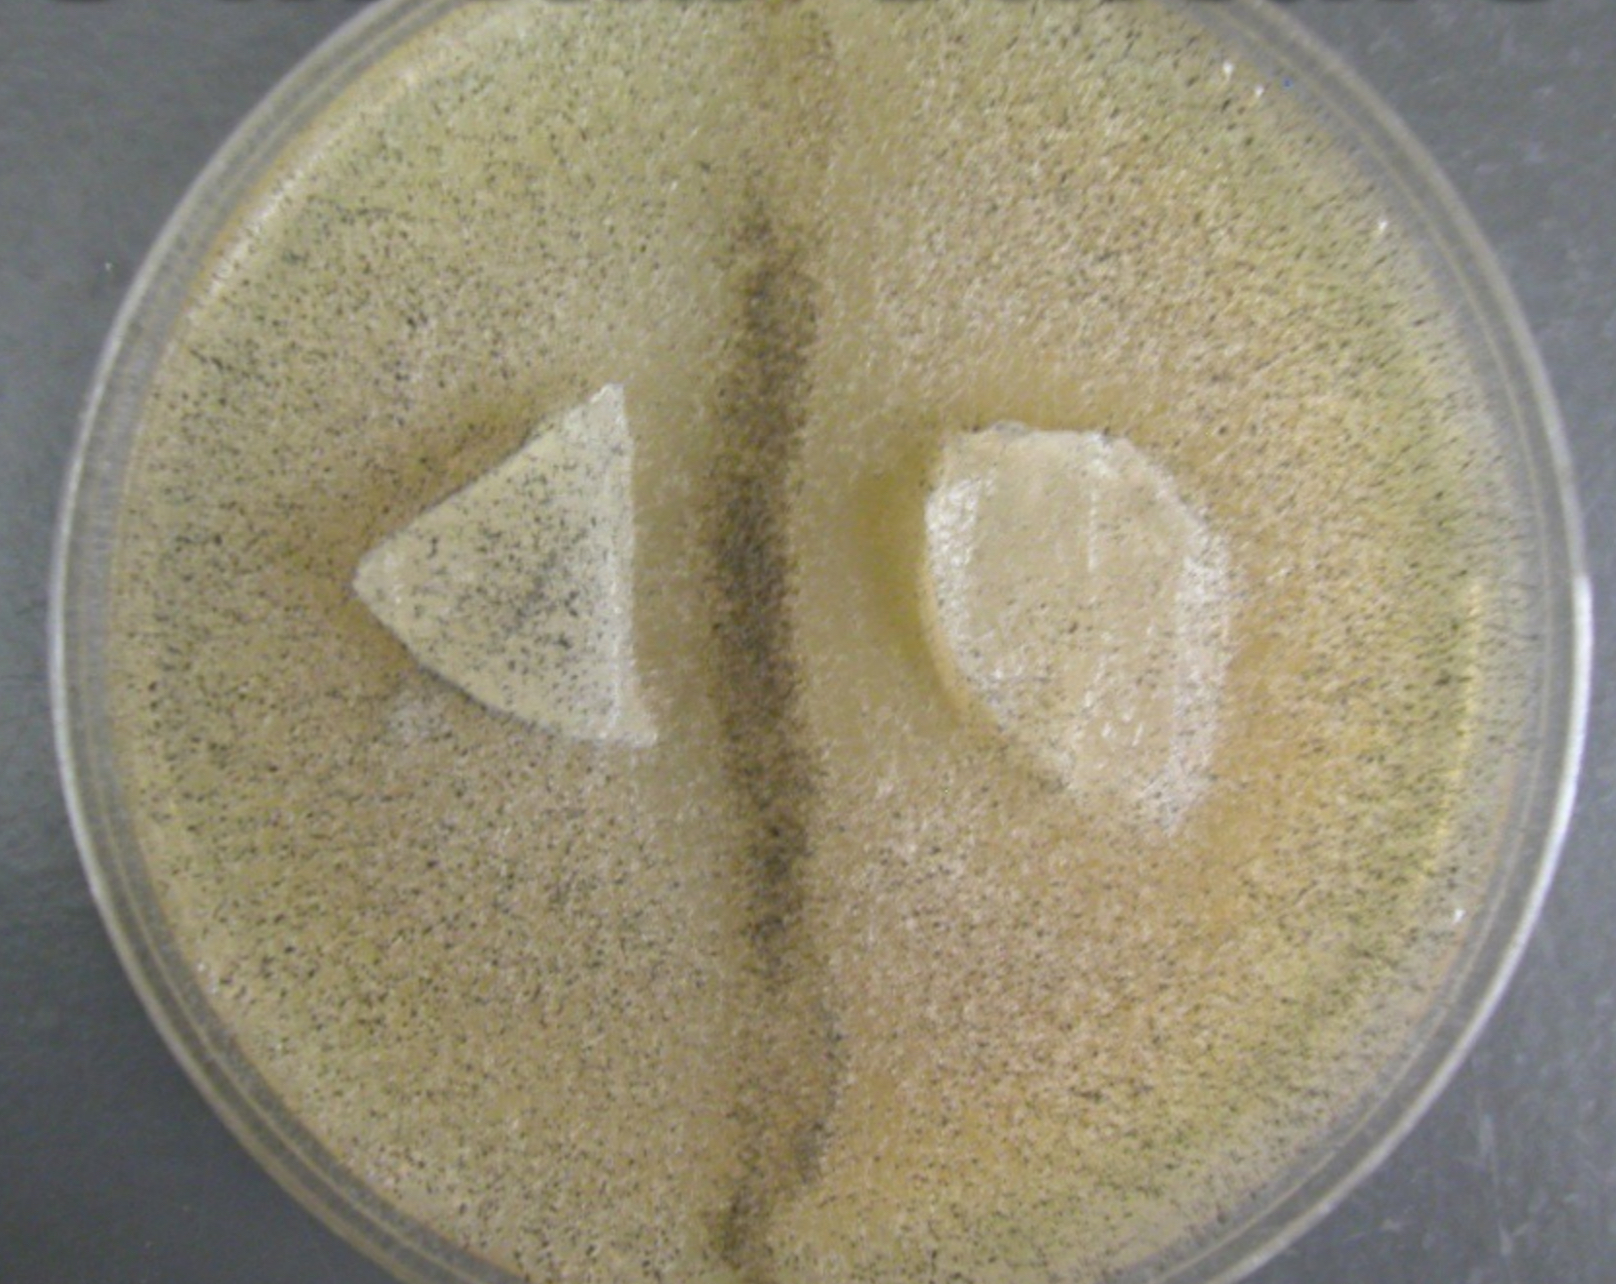

Chytrids zygomycota lab exam
1/59
There's no tags or description
Looks like no tags are added yet.
Name | Mastery | Learn | Test | Matching | Spaced |
|---|
No study sessions yet.
60 Terms

globose with deliquescent wall with zygosporangia that have brown to black roughened wall
Zygorhynchus zygospores

suspensors are opposite and heterogamous , one is as large as zygosporangium, other is not visible
Zygorhynchus zygosporangium

What family is this and what is happening here
phycomycetacea, dehiscing sporangium releasing sporangiospores

What genus is this and what is this structure ?
phycomyces, mature sporangium prior to dehiscence

What is this structure and what is happening
Mature sorus with multiple sporangia/gametangia at leaf epidermis

What is this structure and what is happening
immature sorus surrounded by elongated and enlarged cells

What is seen in this ?
immature sorus and mature sorus on elongated section

What is this structure and what is it doing
resting sporangia under dermis layer 2n phase

what is this and what genus ?
developing sorus , Synchytrium endobioticum

what is this ? and what are its structures
sporothallus with meisporangium containing (N) zoospores, mitosporangia releases (2n) zoospores

what are these structures called
meiosporangia

What is the structure at the top and what is its ploidy
mitosporangia releasing diploid spores

what is this and what is present
branching sporothallus with branching rhizoids

what is this and what is happening
gametangia releasing planogametes

What is this and what is its ploidy
resistant sporangium (N)

what reproductive structures are present here
male and female gametangium

what 3 things are present in this structure
gametothallus, male and female planogametes

what are these structures and what group do they belong to
allomyces branching sporothallus with basal rhizoids

what is this structure and what is it doing
endobiotic thalli living inside of host cell
